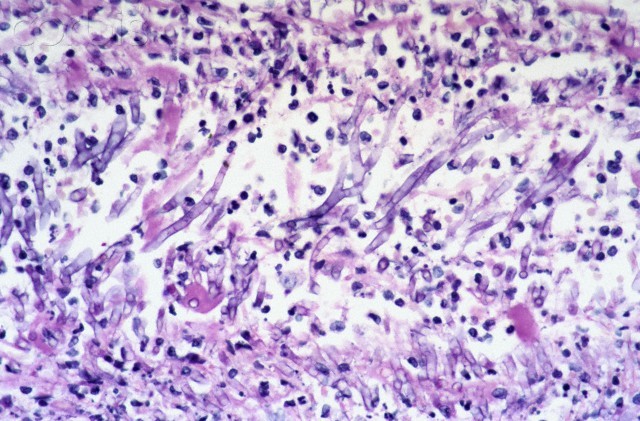

1
Q
Rotavirus: virus type
A
- double-stranded
- linear-segmented
- RNA virus
- no envelope
- **most prevalent cause of viral gastroenteritis in children
2
Q
Rabies: virus type
A
- Rabies = rhabdovirus
- single-stranded
- enveloped
- helical
- RNA virus
3
Q
Tx of Karposi sarcoma
A
alpha-interferon
4
Q
Interferons: MOA
A
- interferons = cytotoxic proteins that interfere w/viral protein expression and DNA synthesis
- types:
- alpha-interferon
- beta-interferon
- gamma-interferon
5
Q
Interferons: uses
A
- alpha-interferon used for leukocytic effects in:
- HepB, HepC
- Karposi’s Sarcoma
- leukemias
- malignant melanoma
- B-interferon
- MS
- y-interferon:
- CGD
6
Q
Dx/identification/tx of Karposi-sarcoma-like lesions
A
- Bartonella ==> bacillary angiomatosis ==> cutaneous lesions ~= Karposi sarcoma
- Dx w/biopsy + Warthin-Starry silver stain
- Tx = erythromycin or doxycycline
7
Q
Presentation of leptospirosis
A
- post-freshwater ingestion
- high fever
- renal impairment
- mild hepatitis
8
Q
Organism + syndromes?

A
- Cryptocuccus neoformans
- stained w/India Ink Stain
- most commonly: fungal meningitis in immunocompromised patients
- 2nd most common: cryptococcal pneumonia
- initial site of innoculation = lung
9
Q
EBV: virus type
A
- **causes mononucleosis
- linear
- double-stranded
- enveloped
- HSVs are only viruses that obtain envelope via budding from nuclear membrane
- DNA virus
10
Q
Agent that causes pneumonia + increased risk for liver cancer
A
aspergillus fumigatus (mold/fungus)
11
Q
Presentation/characteristics of Aspergillus infection
A
- Aspergillus ==> pneumonia/pulmonary disease ==> apergillomas (“fungus balls”)
- fever, malaise, brownish sputum
- Produces aflatoxin ==> increased risk of liver cancer
- Appearance
- mold w/septate hyphae that branch at a V-shaped 45-degree angle

12
Q
Dairy product consumption + spiking fever ==> dx?/characteristics
A
- Brucella melitensis
- intracellular
- ==> fever, weakness, weight loss
- gram-negative coccobacilli
- stain w/modified acid-fast stain
13
Q
Common meningitis cause in unimmunized children
A
- H. influenzae = gram-negative coccobacilli
14
Q
E. coli O157:H7 presentation
A
- undercooked hamburger meat ==> bloody diarrhea
- EHEC (enterohemorrhagic E. Coli) = strain that has acquired Shiga toxin ==> bloody diarrhea, ab pain, mild feer
- complication = hemolytic-uremic syndrome
- low-platelet
- anemia
- renal failure/uremia
15
Q
Shigella presentation/characteristics
A
- Shigella =
- gram-negative
- non-lactose
- oxidase negative
- does not produce hydrogen sulfide (vs. Salmonella does produce Hsulfide)
- ==> bloody diarrhea + fever
- shiga toxin ==> hemolytic uremic syndrome
16
Q
Hanta virus characteristics
A
- bunyavirus ==> hantavirus pulmonary syndrome
- contracted through exposure to deer-mouse dropping
17
Q
Flaviviruses characteristics
A
- Flavivirus ==>
- Dengue fever
- Yellow fever
- West Nile virus = Flavivurs
- Utilizes Aedes mosquito as vector
18
Q
Most common cause of atypical pneumonia (+Dx)
A
- mycoplasma pneumonia
- cannot be cultured
- Dx via cold agglutin test
- cold agglutin = IgM antibodies ==> agglutination of RBCs @ cold temps
- X-ray = patchy interstitial pattern

19
Q
Tx of mot common atypical pneumo
A
- most commone = M. pneumonoiae
- tx = macrolide (usually azithromycin) for 5 days


